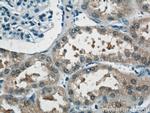
NUDT16 Antibody in Immunohistochemistry (Paraffin) (IHC (P))

Search
Proteintech
NUDT16 Polyclonal Antibody
{{$productOrderCtrl.translations['antibody.pdp.commerceCard.promotion.promotions']}}
{{$productOrderCtrl.translations['antibody.pdp.commerceCard.promotion.viewpromo']}}
{{$productOrderCtrl.translations['antibody.pdp.commerceCard.promotion.promocode']}}: {{promo.promoCode}} {{promo.promoTitle}} {{promo.promoDescription}}. {{$productOrderCtrl.translations['antibody.pdp.commerceCard.promotion.learnmore']}}
产品信息
12889-1-AP
种属反应
已发表种属
宿主/亚型
分类
类型
抗原
偶联物
形式
浓度
规格
纯化类型
保存液
内含物
保存条件
运输条件
产品详细信息
Immunogen sequence: MAGARRLEL GEALALGSGW RHVCHALLYA PDPGMLFGRI PLRYAILMQM RFDGRLGFPG GFVDTQDRSL EDGLNRELRE ELGEAAAAFR VERTDYRSSH VGSGPRVVAH FYAKRLTLEE LLAVEAGATR AKDHGLEVLG LVRVPLYTLR DGVGGLPTFL ENSFIGSARE QLLEALQDLG LLQSGSISGL KIPAHH (1-195 aa encoded by B C031215)
靶标信息
RNA-binding and decapping enzyme that catalyzes the cleavage of the cap structure of snoRNAs and mRNAs in a metal-dependent manner. Part of the U8 snoRNP complex that is required for the accumulation of mature 5.8S and 28S rRNA. Has diphosphatase activity and removes m7G and/or m227G caps from U8 snoRNA and leaves a 5'monophosphate on the RNA. Catalyzes also the cleavage of the cap structure on mRNAs. Does not hydrolyze cap analog structures like 7-methylguanosine nucleoside triphosphate (m7GpppG). Also hydrolysis m7G- and m227G U3-capped RNAs but with less efficiencies. Has broad substrate specificity with manganese or cobalt as cofactor and can act on various RNA species. Binds to the U8 snoRNA; metal is not required for RNA-binding. May play a role in the regulation of snoRNAs and mRNAs degradation. Acts also as a phosphatase; hydrolyzes the non-canonical purine nucleotides inosine diphosphate (IDP) and deoxyinosine diphosphate (dITP) as well as guanosine diphosphate (GDP), deoxyguanosine diphosphate (dGDP), xanthine diphosphate (XDP), inosine triphosphate (ITP) and deoxyinosine triphosphate (ITP) to their respective monophosphate derivatives and does not distinguish between the deoxy- and ribose forms (PubMed:20385596, PubMed:26121039). The order of activity with different substrates is IDP > dIDP >> GDP = dGDP > XDP = ITP = dITP (PubMed:20385596). Binds strongly to GTP, ITP and XTP. Participates in the hydrolysis of dIDP/IDP and probably excludes non-canonical purines from RNA and DNA precursor pools, thus preventing their incorporation into RNA and DNA and avoiding chromosomal lesions (PubMed:20385596). [UniProt]
仅用于科研。不用于诊断过程。未经明确授权不得转售。
生物信息学
蛋白别名: IDP phosphatase; IDPase; Inosine diphosphate phosphatase; m7GpppN-mRNA hydrolase; Nucleoside diphosphate-linked moiety X motif 16; nudix (nucleoside diphosphate linked moiety X)-type motif 16; Nudix hydrolase 16; Nudix motif 16; testicular tissue protein Li 129; U8 snoRNA-binding protein H29K; U8 snoRNA-decapping enzyme; unnamed protein product
基因别名: NUDT16
UniProt ID: (Human) Q96DE0
Entrez Gene ID: (Human) 131870